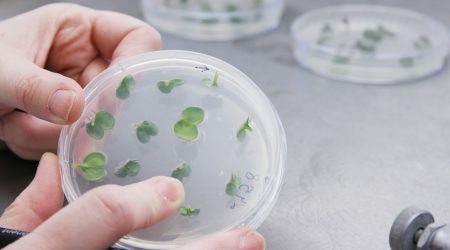

Using ‘chemical origami’ to generate customisable, high-value chemicals from plants
Following the discovery of a new and very valuable enzyme which folds linear molecules into different shapes, scientists are building a ‘triterpene machine’ which will enable them to custom-build valuable chemical compounds called triterpenes and produce them in large, cost-effective quantities
Read the story